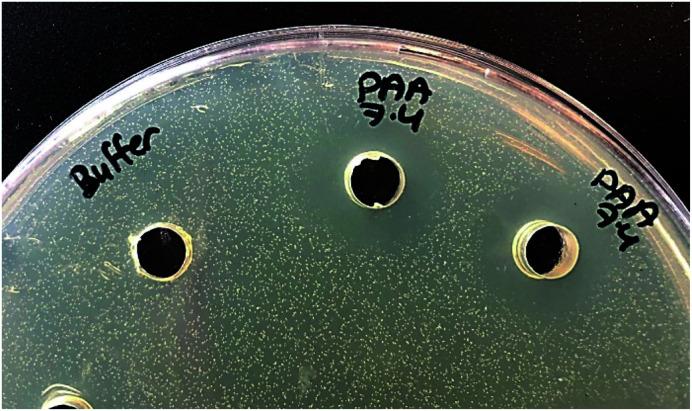
https://cdn.ncbi.nlm.nih.gov/pmc/blobs/55ab/9050377/a5b7cb1fa42b/c9ra10135g-f9.jpg

乳酸链球菌素/聚阴离子层层组装膜在抗菌效果上表现出不同机制。
Nisin/polyanion layer-by-layer films exhibiting different mechanisms in antimicrobial efficacy.
作者信息
Fael Hanan, Demirel A Levent
机构信息
Department of Chemistry, Koç University Istanbul Turkey
出版信息
RSC Adv. 2020 Mar 11;10(17):10329-10337. doi: 10.1039/c9ra10135g. eCollection 2020 Mar 6.
Nisin/polyanion Layer-by-Layer (LbL) films are reported to exhibit different mechanisms in antimicrobial efficacy depending on the type of polyanion. LbL films consisting of nisin as the polycationic component were prepared using two different polyanionic constituents: poly acrylic acid (PAA) and dextran sulfate (DX). Due to the weaker interaction strength of carboxylate groups with nisin compared to sulfate/nisin, a larger molecular weight of PAA was needed to achieve LbL assembly. PAA-100K/nisin and DX-15K/nisin multilayer films exhibited significantly different properties. PAA-nisin films grew faster compared to DX-nisin films and showed, for 60 bilayer films, an average bilayer thickness of 21.6 nm compared to that of 6.1 nm in DX-nisin films. The total amount of nisin was found to be 17.1 ± 2.2 μg cm in (PAA-nisin) and 6.8 ± 0.4 μg cm in (DX-nisin) films. The stability of the films was investigated at three different pH values of 6.0, 7.4 and 9.5. (PAA-nisin) films exhibited the release of nisin into the solution which resulted in the disintegration of the film over several hours. A burst release was observed in the first hour followed by a slower release and disintegration over 24 hours with a complete release at pH 9.5. The bacterial growth inhibition test against confirmed the antimicrobial activity of nisin released from PAA-nisin films. PAA was found to stabilize nisin and the film-released nisin retained its antimicrobial activity in the neutral and alkaline pH values. Unlike PAA-nisin films, (DX-nisin) films were stable at the physiological conditions up to 14 days with no release of nisin. DX-nisin films were found to inhibit the attachment of and prevent biofilm formation. These results clearly demonstrate the effect of different polyanions on nisin LbL films to achieve different mechanisms in antimicrobial efficacy and show the potential of PAA-nisin multilayer films as promising local delivery systems for treatment of burns and wounds, while DX-nisin multilayer films can be employed as stable coatings against bacterial attachment and biofilm formation.
据报道,乳链菌肽/聚阴离子层层(LbL)膜根据聚阴离子的类型在抗菌效果上表现出不同的机制。使用两种不同的聚阴离子成分制备了以乳链菌肽为聚阳离子成分的LbL膜:聚丙烯酸(PAA)和硫酸葡聚糖(DX)。由于与硫酸根/乳链菌肽相比,羧酸根基团与乳链菌肽的相互作用强度较弱,因此需要更大分子量的PAA来实现LbL组装。PAA - 100K/乳链菌肽和DX - 15K/乳链菌肽多层膜表现出显著不同的性质。与DX -乳链菌肽膜相比,PAA -乳链菌肽膜生长更快,对于60个双层膜,其平均双层厚度为21.6 nm,而DX -乳链菌肽膜为6.1 nm。发现乳链菌肽的总量在(PAA -乳链菌肽)膜中为17.1±2.2μg/cm²,在(DX -乳链菌肽)膜中为6.8±0.4μg/cm²。在6.0、7.4和9.5三个不同pH值下研究了膜的稳定性。(PAA -乳链菌肽)膜表现出乳链菌肽释放到溶液中,导致膜在数小时内解体。在第一个小时观察到爆发式释放,随后在24小时内释放和分解较慢,在pH 9.5时完全释放。针对[具体细菌名称未给出]的细菌生长抑制试验证实了从PAA -乳链菌肽膜释放的乳链菌肽的抗菌活性。发现PAA可稳定乳链菌肽,并且膜释放的乳链菌肽在中性和碱性pH值下保持其抗菌活性。与PAA -乳链菌肽膜不同,(DX -乳链菌肽)膜在生理条件下稳定长达14天,没有乳链菌肽释放。发现DX -乳链菌肽膜可抑制[具体细菌名称未给出]的附着并防止生物膜形成。这些结果清楚地证明了不同聚阴离子对乳链菌肽LbL膜的影响,以实现抗菌效果的不同机制,并表明PAA -乳链菌肽多层膜作为治疗烧伤和伤口的有前景的局部递送系统的潜力,而DX -乳链菌肽多层膜可作为防止细菌附着和生物膜形成的稳定涂层。